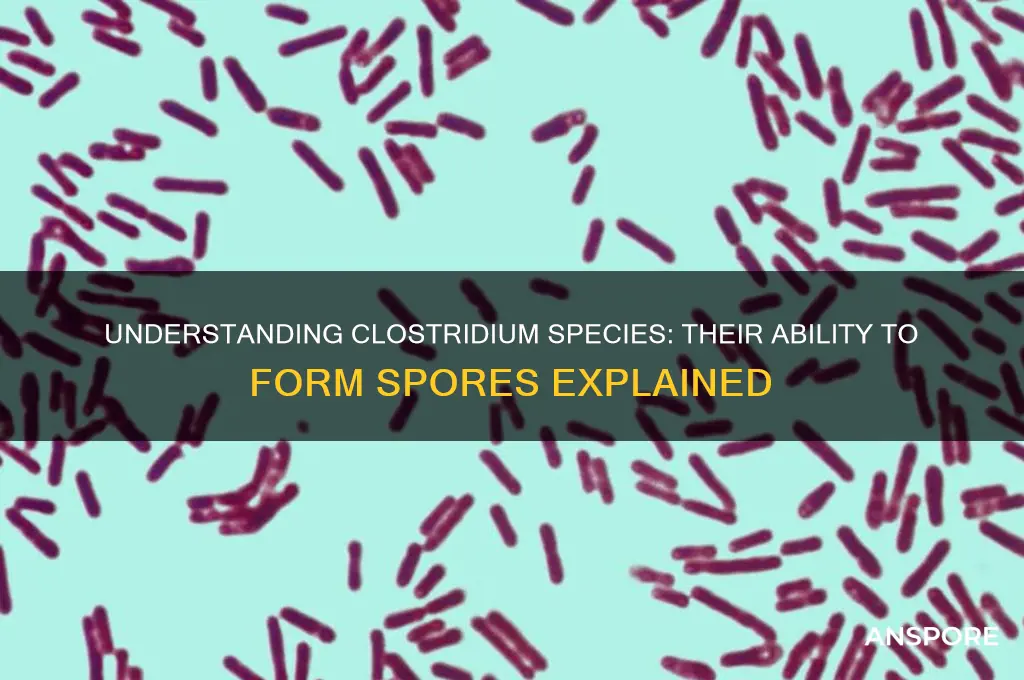
can clostridium species form spores

Clostridium species are a diverse group of Gram-positive, anaerobic bacteria known for their ability to produce endospores, which are highly resistant structures that allow them to survive harsh environmental conditions such as heat, desiccation, and exposure to chemicals. This spore-forming capability is a defining characteristic of the genus and plays a crucial role in their persistence in various ecosystems, including soil, water, and the gastrointestinal tracts of animals and humans. Understanding whether and how Clostridium species form spores is essential for studying their ecology, pathogenicity, and potential applications in biotechnology, as well as for developing effective strategies to control infections caused by spore-forming pathogens like *Clostridium difficile* and *Clostridium botulinum*.
| Characteristics | Values |
|---|---|
| Spore Formation | Yes, most Clostridium species are spore-forming (endospore-producing) |
| Spore Location | Spores are formed within the bacterial cell (endospores) |
| Spore Shape | Oval or spherical, depending on the species |
| Spore Function | Serve as a survival mechanism in harsh conditions (e.g., heat, desiccation, chemicals) |
| Spore Resistance | Highly resistant to extreme temperatures, radiation, and disinfectants |
| Germination | Spores can germinate into vegetative cells when conditions become favorable |
| Species Variability | Not all Clostridium species form spores; some are non-spore-forming (e.g., Clostridium difficile in certain conditions) |
| Clinical Significance | Spore-forming ability contributes to the persistence and transmission of Clostridium infections |
| Detection | Spores can be detected using staining techniques (e.g., Schaeffer-Fulton stain) or molecular methods |
| Environmental Survival | Spores can survive in soil, water, and healthcare environments for extended periods |
Explore related products
What You'll Learn
- Sporulation Conditions: Environmental triggers like nutrient depletion and pH changes induce Clostridium spore formation
- Spore Structure: Clostridium spores have a thick, protective coat and cortex for survival
- Germination Process: Spores activate and return to vegetative state under favorable conditions
- Species Variability: Not all Clostridium species form spores; depends on genetic and environmental factors
- Clinical Significance: Spores resist harsh conditions, complicating treatment of Clostridium infections

Sporulation Conditions: Environmental triggers like nutrient depletion and pH changes induce Clostridium spore formation
Clostridium species are renowned for their ability to form highly resistant spores, a survival mechanism triggered by specific environmental conditions. Among these, nutrient depletion and pH changes stand out as critical factors that induce sporulation. When the availability of essential nutrients like carbon and nitrogen drops below a certain threshold, Clostridium cells initiate a complex genetic program leading to spore formation. For instance, studies have shown that a reduction in glucose concentration to below 0.1% in the growth medium can significantly accelerate sporulation in *Clostridium perfringens*. Similarly, a shift in pH, particularly toward more acidic or alkaline conditions, can act as a potent trigger. A pH drop from 7.0 to 5.5 has been observed to induce spore formation in *Clostridium botulinum*, highlighting the sensitivity of these organisms to environmental pH.
Understanding the precise conditions that trigger sporulation is crucial for both laboratory research and industrial applications. In a laboratory setting, researchers often manipulate nutrient levels and pH to study sporulation dynamics. For example, to induce sporulation in *Clostridium difficile*, a common protocol involves transferring cells from a nutrient-rich medium (e.g., brain heart infusion broth) to a nutrient-depleted medium (e.g., DH minimal medium) and adjusting the pH to 7.4. This controlled environment mimics the stress conditions that Clostridium encounters in nature, prompting spore formation. In industrial contexts, such as food preservation, knowing these triggers helps in designing strategies to prevent unwanted sporulation, which can lead to food spoilage or contamination.
From a persuasive standpoint, recognizing the role of nutrient depletion and pH changes in sporulation underscores the importance of environmental monitoring in controlling Clostridium populations. For instance, in food processing plants, maintaining optimal nutrient levels and pH in processing environments can inhibit spore formation, reducing the risk of contamination by pathogens like *Clostridium botulinum*. Similarly, in healthcare settings, understanding these triggers can inform disinfection protocols, as spores are notoriously resistant to standard cleaning agents. By targeting the conditions that induce sporulation, industries can adopt more effective preventive measures, safeguarding both products and public health.
Comparatively, the sporulation triggers of Clostridium species differ from those of other spore-forming bacteria, such as Bacillus. While Bacillus species often respond to oxygen limitation as a primary sporulation signal, Clostridium species are strictly anaerobic and rely more heavily on nutrient depletion and pH changes. This distinction highlights the unique ecological niche of Clostridium and the need for tailored strategies to manage their sporulation. For example, in wastewater treatment plants, where Clostridium species are prevalent, monitoring nutrient levels and pH can help control spore formation, ensuring more efficient treatment processes.
In conclusion, nutrient depletion and pH changes are pivotal environmental triggers that induce sporulation in Clostridium species. By manipulating these conditions in controlled settings, researchers and industries can study sporulation dynamics and implement preventive measures to mitigate risks associated with Clostridium spores. Whether in a laboratory, food processing plant, or healthcare facility, understanding these triggers is essential for managing the unique challenges posed by these resilient organisms. Practical tips include regularly monitoring nutrient concentrations and pH in at-risk environments, using nutrient-depleted media for sporulation studies, and adjusting pH levels to discourage spore formation in industrial processes. Such targeted approaches can significantly enhance control over Clostridium populations, ensuring safety and efficiency across various applications.
Breathing Lichen Spores: Potential Health Risks and Safety Concerns
You may want to see also

Spore Structure: Clostridium spores have a thick, protective coat and cortex for survival
Clostridium species are renowned for their ability to form highly resilient spores, a trait that underpins their survival in harsh environments. Central to this resilience is the spore’s intricate structure, specifically its thick, protective coat and cortex. These layers serve as a biological fortress, shielding the spore’s genetic material from extreme conditions such as heat, desiccation, and chemical exposure. Understanding this structure is crucial for fields like microbiology, medicine, and food safety, where Clostridium spores pose both challenges and opportunities.
The cortex, an outer layer composed primarily of peptidoglycan, acts as the first line of defense. Its high density and cross-linked structure provide mechanical strength, enabling the spore to withstand physical stress. Surrounding the cortex is the coat, a proteinaceous layer that further enhances durability. This coat is not merely a passive barrier; it contains enzymes and proteins that repair DNA damage and maintain spore viability. Together, these layers create a multi-tiered defense system that allows Clostridium spores to persist in environments where most other microorganisms would perish.
To appreciate the significance of this structure, consider the practical implications. In healthcare, Clostridium difficile spores can survive on hospital surfaces for months, contributing to healthcare-associated infections. Decontamination protocols often require high-temperature steam sterilization (autoclaving at 121°C for 15–30 minutes) to destroy these spores, highlighting the robustness of their protective layers. Similarly, in the food industry, Clostridium botulinum spores can survive standard cooking temperatures, necessitating specific preservation techniques like pressure canning to ensure food safety.
For researchers and practitioners, understanding the spore structure opens avenues for targeted interventions. For instance, developing antimicrobial agents that disrupt the coat or cortex could render spores vulnerable. Alternatively, studying these layers can inspire biomimetic designs for protective materials in engineering or medicine. Practical tips include using spore-specific disinfectants like chlorine-based solutions for surface decontamination and ensuring proper heating (above 80°C for extended periods) to eliminate spores in food processing.
In conclusion, the thick, protective coat and cortex of Clostridium spores are not just biological curiosities but critical survival mechanisms with far-reaching implications. By dissecting their structure and function, we gain insights into combating spore-related challenges while harnessing their resilience for innovative applications. This knowledge bridges the gap between fundamental microbiology and practical problem-solving, making it an indispensable tool for anyone dealing with Clostridium species.
Are Spore Kits Legal? Understanding the Laws and Regulations
You may want to see also

Germination Process: Spores activate and return to vegetative state under favorable conditions
Clostridium species are renowned for their ability to form highly resistant spores, a survival mechanism that allows them to endure harsh environmental conditions. These spores remain dormant until they encounter favorable conditions, at which point they germinate, reactivating the bacterium’s metabolic processes and returning it to a vegetative, growth-capable state. This germination process is critical for the persistence and spread of Clostridium in diverse environments, from soil to the human gut.
Triggering Germination: The Role of Nutrients and Temperature
Germination begins when spores detect specific environmental cues, primarily the presence of nutrients such as amino acids, sugars, or purine bases. For instance, *Clostridium perfringens* spores require glycine and other nutrients to initiate germination. Temperature also plays a pivotal role; most Clostridium species germinate optimally between 25°C and 37°C, mirroring their natural habitats. In clinical settings, this knowledge is crucial: improperly stored food at temperatures within this range can inadvertently trigger spore germination, leading to foodborne illnesses.
Steps in the Germination Process: From Dormancy to Activity
The germination process unfolds in stages. First, spores release dipicolinic acid (DPA), a calcium-bound molecule that stabilizes the spore’s structure during dormancy. This release is followed by rehydration and the activation of enzymes like germinant receptors. For example, *Clostridium botulinum* spores utilize specific germinant receptors to detect L-alanine and inosine, initiating the transition to the vegetative state. Understanding these steps is essential for developing strategies to inhibit germination, such as targeting germinant receptors or disrupting DPA release.
Practical Implications: Preventing Germination in Food and Medicine
In food safety, preventing spore germination is paramount. Techniques like proper heating (above 75°C for at least 10 minutes) can destroy spores, while refrigeration (below 4°C) slows germination. For medical applications, antibiotics such as metronidazole and vancomycin target vegetative Clostridium cells, but their effectiveness depends on preventing spore germination first. Probiotics containing competitive microorganisms can also outcompete Clostridium for nutrients, reducing germination opportunities in the gut.
Comparative Perspective: Clostridium vs. Other Spore-Formers
Unlike *Bacillus* species, which often require oxygen for germination, Clostridium spores are strictly anaerobic. This distinction highlights the adaptability of Clostridium to oxygen-deprived environments, such as the intestinal tract. Additionally, while *Bacillus* spores germinate rapidly, Clostridium spores may exhibit longer lag phases, reflecting their evolutionary specialization for survival in nutrient-limited conditions. This comparison underscores the need for tailored strategies to manage Clostridium germination in different contexts.
By understanding the germination process of Clostridium spores, we can devise targeted interventions to control their activation, whether in food preservation, clinical settings, or environmental management. This knowledge bridges the gap between microbiology and practical applications, offering actionable insights for preventing spore-related challenges.
Tetanus Spores in Bleeding Wounds: Survival and Risks Explained
You may want to see also
Explore related products

Species Variability: Not all Clostridium species form spores; depends on genetic and environmental factors
Clostridium, a diverse genus of bacteria, is often synonymous with spore formation, a survival mechanism that allows these microbes to endure harsh conditions. However, this generalization overlooks a critical aspect: not all Clostridium species form spores. This variability is a fascinating example of how genetic and environmental factors shape microbial behavior, challenging the assumption that spore formation is a universal trait within the genus.
Consider the Clostridium difficile, a well-known pathogen responsible for antibiotic-associated diarrhea. Despite its notoriety, C. difficile does not form spores under typical laboratory conditions. Its ability to cause disease relies instead on toxin production and rapid vegetative growth. In contrast, Clostridium botulinum, the causative agent of botulism, is a prolific spore former. These spores can survive extreme temperatures, pH levels, and even some disinfectants, making them a significant food safety concern. The difference between these two species highlights how genetic makeup dictates their survival strategies.
Environmental factors also play a pivotal role in spore formation. For species that are genetically capable of sporulation, the process is often triggered by nutrient deprivation, oxygen limitation, or other stress conditions. For instance, Clostridium perfringens, a common cause of food poisoning, forms spores in response to environmental stress, such as exposure to high temperatures during cooking. However, if the environment remains nutrient-rich and stable, sporulation may be suppressed. This interplay between genetics and environment underscores the complexity of spore formation in Clostridium species.
Understanding this variability has practical implications, particularly in clinical and industrial settings. For example, in healthcare, knowing whether a Clostridium species forms spores is crucial for selecting effective disinfection methods. Spores require more aggressive measures, such as autoclaving at 121°C for 15–30 minutes, compared to vegetative cells, which can often be eliminated with standard disinfectants. In biotechnology, spore-forming Clostridium species like Clostridium acetobutylicum are used in biofuel production, where their ability to sporulate can impact fermentation efficiency.
To navigate this variability, researchers and practitioners should adopt a species-specific approach. Start by identifying the exact Clostridium species in question, as this determines its sporulation potential. For species capable of sporulation, monitor environmental conditions closely, as even slight changes can influence spore formation. Finally, tailor control measures accordingly—whether it’s enhancing disinfection protocols for spore formers or optimizing growth conditions for non-spore formers in industrial applications. This targeted strategy ensures both safety and efficiency in handling Clostridium species.
Mold Spores: Are They Truly Everywhere in Our Environment?
You may want to see also

Clinical Significance: Spores resist harsh conditions, complicating treatment of Clostridium infections
Clostridium species are notorious for their ability to form highly resilient spores, a survival mechanism that poses significant challenges in clinical settings. These spores can withstand extreme conditions, including heat, desiccation, and exposure to antibiotics, making them a formidable adversary in the treatment of Clostridium infections. For instance, *Clostridium difficile*, a leading cause of hospital-acquired infections, produces spores that persist on surfaces for months, facilitating transmission even in sterile environments. This resilience necessitates stringent disinfection protocols, such as using spore-specific agents like chlorine bleach (5,000 ppm), to reduce environmental contamination.
The clinical implications of spore resistance are profound, particularly in immunocompromised patients or those with recurrent infections. Spores can remain dormant in the gut or environment until conditions favor germination, leading to relapse or reinfection. For example, standard antibiotic therapies, such as metronidazole (500 mg every 8 hours) or vancomycin (125 mg every 6 hours), target actively growing bacteria but are ineffective against spores. This limitation often results in treatment failure, as surviving spores can regenerate the infection once antibiotic pressure is removed. Clinicians must therefore adopt a dual approach: eradicating vegetative cells while preventing spore germination, which may involve adjunctive therapies like fecal microbiota transplantation (FMT) to restore gut flora balance.
From a comparative perspective, the spore-forming ability of Clostridium species contrasts sharply with non-spore-forming pathogens, which are generally more susceptible to standard disinfection and antibiotic regimens. For instance, while *Escherichia coli* can be eliminated with routine cleaning agents, Clostridium spores require specialized procedures, such as autoclaving at 121°C for 15 minutes, to ensure destruction. This disparity highlights the need for tailored infection control strategies in healthcare settings, particularly in high-risk areas like intensive care units and surgical wards.
Practically, managing Clostridium infections requires a proactive and multifaceted approach. Patients should be educated on hygiene measures, such as handwashing with soap and water (alcohol-based sanitizers are ineffective against spores), to minimize transmission. Healthcare providers must also be vigilant in identifying high-risk populations, including the elderly, individuals on prolonged antibiotic therapy, and those with underlying gastrointestinal disorders. For recurrent *C. difficile* infections, emerging treatments like bezlotoxumab, a monoclonal antibody targeting toxin B, offer promising alternatives by neutralizing virulence factors and reducing recurrence rates.
In conclusion, the spore-forming capacity of Clostridium species represents a critical clinical challenge, demanding innovative treatment strategies and rigorous infection control practices. By understanding the unique biology of these spores and their resistance mechanisms, healthcare professionals can more effectively combat Clostridium infections, improving patient outcomes and reducing the burden of healthcare-associated diseases.
Are Spore-Based Probiotics Safe for Your Gut Health?
You may want to see also
Frequently asked questions
No, not all Clostridium species can form spores. While many Clostridium species are known for their ability to produce endospores, some species within the genus are non-spore-forming.
Clostridium species typically form spores in response to adverse environmental conditions, such as nutrient depletion, oxygen exposure, or extreme temperatures. This process is a survival mechanism.
Clostridium spores themselves are generally not harmful, but they can germinate into active bacteria under favorable conditions. Some species, like *Clostridium botulinum* and *Clostridium difficile*, can cause serious infections or diseases when they become active.
Clostridium spores are highly resistant and can survive in the environment for years, even under harsh conditions such as heat, desiccation, and exposure to chemicals. This makes them difficult to eradicate.



















![Substances screened for ability to reduce thermal resistance of bacterial spores 1959 [Hardcover]](https://m.media-amazon.com/images/I/51Z99EgARVL._AC_UL320_.jpg)





